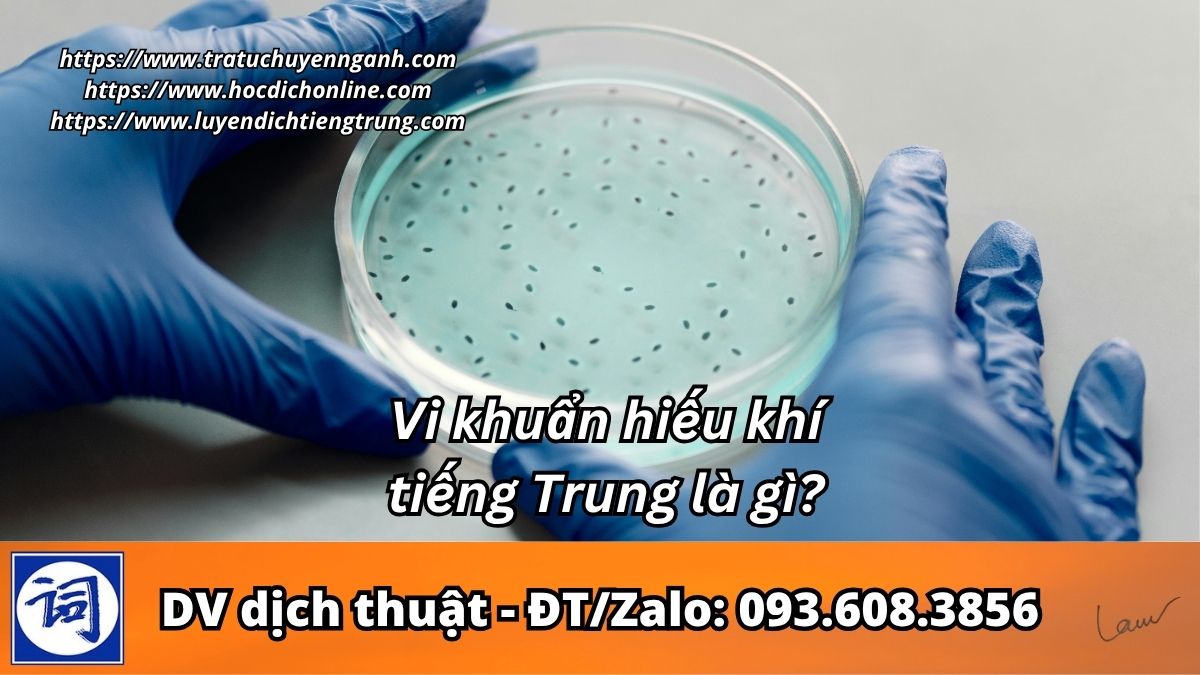
Vi khuẩn hiếu khí tiếng Trung là gì?

Vi khuẩn hiếu khí tiếng Trung là gì?
Vi khuẩn hiếu khí là gì?
Vi khuẩn hiếu khí là nhóm vi sinh vật phát triển và sinh trưởng trong môi trường có oxy. Chúng sử dụng oxy để thực hiện các phản ứng trao đổi chất, phân hủy chất hữu cơ và tham gia vào nhiều quá trình sinh học tự nhiên như xử lý nước thải, phân hủy rác thải và chuyển hóa chất trong môi trường.
Admin nhận dịch thuật văn bản các chuyên ngành – CHI PHÍ HỢP LÝ – ĐT/ZALO: 0936083856
Đăng ký thành viên để làm BÀI TẬP LUYỆN DỊCH TIẾNG TRUNG CẤP ĐỘ DỄ – MIỄN PHÍ
| Tiếng Trung giản thể | 好氧细菌 (hǎo yǎng xì jūn) (Danh từ) |
| 繁體字 | 好氧細菌 |
| English: | Aerobic bacteria |
Ví dụ tiếng Trung với từ 好氧细菌
好氧细菌需要氧气才能生存和繁殖。
Vi khuẩn hiếu khí cần oxy để tồn tại và sinh sản.
Aerobic bacteria require oxygen to survive and reproduce.
Từ vựng liên quan
- 氧气 (yǎng qì) – Oxy
- 代谢 (dài xiè) – Trao đổi chất
- 微生物 (wēi shēng wù) – Vi sinh vật
Quay lại Trang chủ tham khảo từ mới cập nhật và SHOP TỪ ĐIỂN CHUYÊN NGÀNH
Đặc điểm của vi khuẩn hiếu khí
Vi khuẩn hiếu khí phát triển mạnh trong môi trường giàu oxy và tham gia tích cực vào quá trình phân hủy sinh học. Chúng có khả năng chuyển hóa chất hữu cơ, hỗ trợ làm sạch môi trường, đặc biệt trong hệ thống xử lý nước thải hiếu khí. Một số loài còn đóng vai trò quan trọng trong y học và công nghệ sinh học.
Join group TỪ ĐIỂN TIẾNG TRUNG để cập nhật từ mới nhanh nhất nhé!
Ứng dụng thực tế
Vi khuẩn hiếu khí được ứng dụng rộng rãi trong ngành môi trường, đặc biệt là công nghệ xử lý nước thải bằng phương pháp hiếu khí. Chúng giúp phân giải các chất hữu cơ, giảm thiểu ô nhiễm và cải thiện chất lượng nước. Ngoài ra, vi khuẩn hiếu khí còn được sử dụng trong sản xuất phân bón hữu cơ và các quá trình sinh học công nghiệp.



